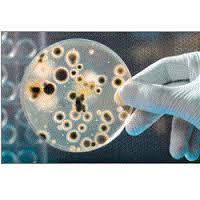

Ahmedabad, Gujarat, India|GST 24AGMPP7099L1ZI|
Comet Chemicals - Ro Plant Chemicals (7)
GST
24AGMPP7099L1ZI
Proprietor
Mr Manager
Address
FF-01, Block C 2, Nirman Complex, R C Technical Road, Ghatlodiya, Ahmedabad, Gujarat, 380061, India
We are well established firm offering Ro Plant Chemicals including RO Membrane Cleaning Chemicals, Ro Antiscalant, Cooling Water Antiscalant that are highly demanded among the clients.
All Categories
Seller Details
Proprietor
Mr Manager
Address
FF-01, Block C 2, Nirman Complex, R C Technical Road, Ghatlodiya, Ahmedabad, Gujarat, 380061, India
Get the Best Price for
Comet ChemicalsRegister your
Company
Popular Products
Human HairForklift TrucksServo Voltage StabilizerBasmati RiceBackhoe LoaderCarry Bag Making MachineDrum LifterElectric StackerScissor LiftsIndustrial Vibrating ScreenRotameterFlowmeterRotary Air CompressorIndustrial Eto SterilizerRice Packaging MachinesShredding MachineHammer MillAutomatic Labelling MachineDiesel ForkliftAerial Work PlatformStorage Rack SystemEpoxy ResinMild Steel BarStainless Steel SheetsStainless Steel StripsBag Filling MachinesAsphalt PlantsSlat ConveyorOintment PlantPlanetary MixersLadies KurtisLed LightsCctv CameraBall ValveAnti Cancer MedicineAir CompressorIncense SticksSolar LightsGoods LiftsVitrified TilesStainless Steel CoilsPvc PipesPvc Pipe FittingsUpvc PipesUpvc Ball ValvePipe Elbows